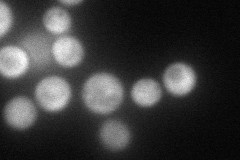
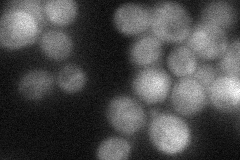
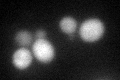
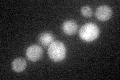

View description
Asn and gln rich protein of unknown function; high-copy suppressor of POL1 (DNA polymerase alpha) and partial suppressor of CDC2 (polymerase delta) and CDC6 (pre-RC loading factor) mutations; overexpression results in growth inhibition
Localization:
Intensity:
Fold change:
Significance:
-
C’ GFP library in SD

cytosol33.51 -
N' NOP1pr-GFP in SD

cytosol63.186 -
N' TEF2pr-mCherry in SD
cytosol107.589 -
N' NATIVEpr-GFP in SD
cytosol40.3387 -
N' TEF2pr-VC and Cyto-VN in SD

#N/A0 -
C’ GFP library in SD+DTT
cytosol28.440.84No -
C’ GFP library in SD+H2O2

cytosol32.210.96No -
C’ GFP library in Starvation Media
cytosol34.211.02No -
C’ GFP library on the background of Pup2-DaMP

cytosol -
C’ GFP library on the background of CCT mutant

cytosol39.11141.16695No
